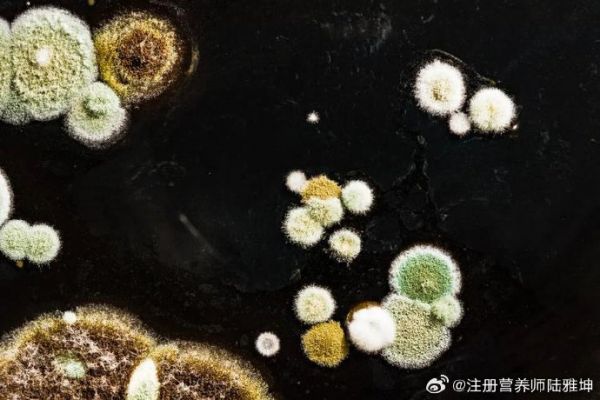

#过年大扫除如何搞定过敏原##把健康带回家##今年过年超会爱自己#
【居家“潜伏者”:揪出家中主要过敏原】
家是温暖的港湾,但也可能潜藏着引发过敏反应的“元凶”。了解并管理它们,对健康至关重要~
[举手][举手]主要过敏原与藏身处:
1. 尘螨及其排泄物:最主要的室内过敏原。它们以人体皮屑为食,高度集中于床垫、枕头、被褥、地毯和软体家具中。温暖潮湿的环境使其大量繁殖。
2. 霉菌孢子:喜欢潮湿环境,常见于卫生间墙角、厨房水槽、窗台、地下室以及漏水或受潮的墙面、绿植盆栽土壤中。
3. 宠物皮屑、唾液:猫、狗等宠物的过敏原不仅附着在毛发上,更微小的皮屑和干燥的唾液能长期飘散在空气中,并附着于沙发、窗帘、衣物各处。
4. 蟑螂及其排泄物:特别是老旧住宅,厨房橱柜、电器后方、下水管道附近是其活跃区,其分泌物是强过敏原。
5. 花粉:季节性过敏原,主要通过门窗、通风口进入,并沉降在地面、家具表面。
6. 食物过敏原:如花生、牛奶、海鲜等,厨房是主要区域。微小的颗粒可能残留在案板、餐具或通过接触污染其他表面。
[举手][举手]营养与过敏管理小贴士:
保持均衡营养,补充维生素C、Omega-3脂肪酸等有助于维持免疫系统平衡。
同时,定期清洁、保持干燥、使用防螨寝具、高效空气净化器,并妥善储存食物,是减少过敏原暴露的关键步骤。若过敏症状持续,请及时就医进行过敏原检测。
#720宠物空气净化器p5##过年大扫除##环境污染#
发布于 山西





